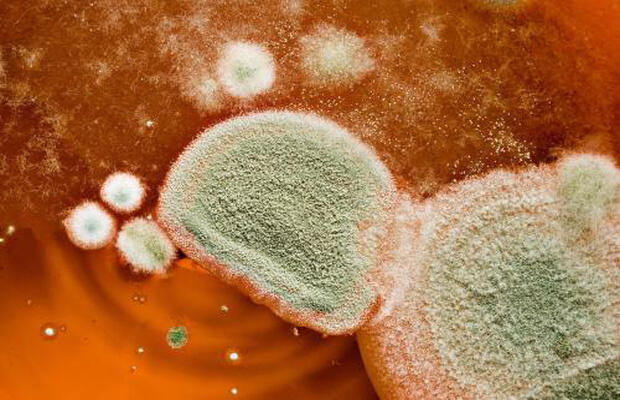
食品中真菌毒素检测项目及收费

办理一份食品中真菌毒素检测报告的费用大概在 500 至 3000 元左右。
一、检测费用明细
具体收费根据检测项目数量与样品基质复杂程度而定,以下是常见项目预估价格:
| 检测项目 | 预估价格 |
| 黄曲霉毒素 B1 | 500-800 元 |
| 赭曲霉毒素 A | 600-900 元 |
| 呕吐毒素 | 500-800 元 |
| 玉米赤霉烯酮 | 600-1000 元 |
| 全套真菌毒素筛查 | 2000-3000 元 |
二、费用影响因素
检测总费用主要由以下三个方面决定:
- 项目数量:单项检测价格较低,多项组合套餐更具性价比。
- 机构差异:具备 CNAS 和 CMA 资质的实验室收费略高,数据更具公信力。
- 标准不同:执行国标方法与企标方法成本不同,精密仪器检测费用较高。
三、检测标准
产品执行标准概览:
- GB 2761-2017 食品安全国家标准 食品中真菌毒素限量
- GB 5009.22-2016 食品安全国家标准 食品中黄曲霉毒素 B 族和 G 族的测定
- GB 5009.96-2016 食品安全国家标准 食品中赭曲霉毒素 A 的测定
- GB 5009.111-2016 食品安全国家标准 食品中脱氧雪腐镰刀菌烯醇及其乙酰化衍生物的测定
- 可根据客户需要标准进行检测
总结
本文概述了食品真菌毒素检测的主要收费区间与明细构成,明确了影响价格的核心因素与执行国家标准。通过透明的价格列表与标准解读,为相关企业提供清晰的预算参考,确保检测工作有序进行,保障产品质量符合法规要求。
汇策集团海沣检测拥有 CNAS 和 CMA 双重资质,配备液相色谱质谱联用仪等先进设备,具备精准检测真菌毒素的技术能力。实验室环境符合国际标准,数据权威可靠,广泛服务于食品生产企业与监管机构。欢迎联系专业工程师获取定制检测方案。
alt="微信二维码">